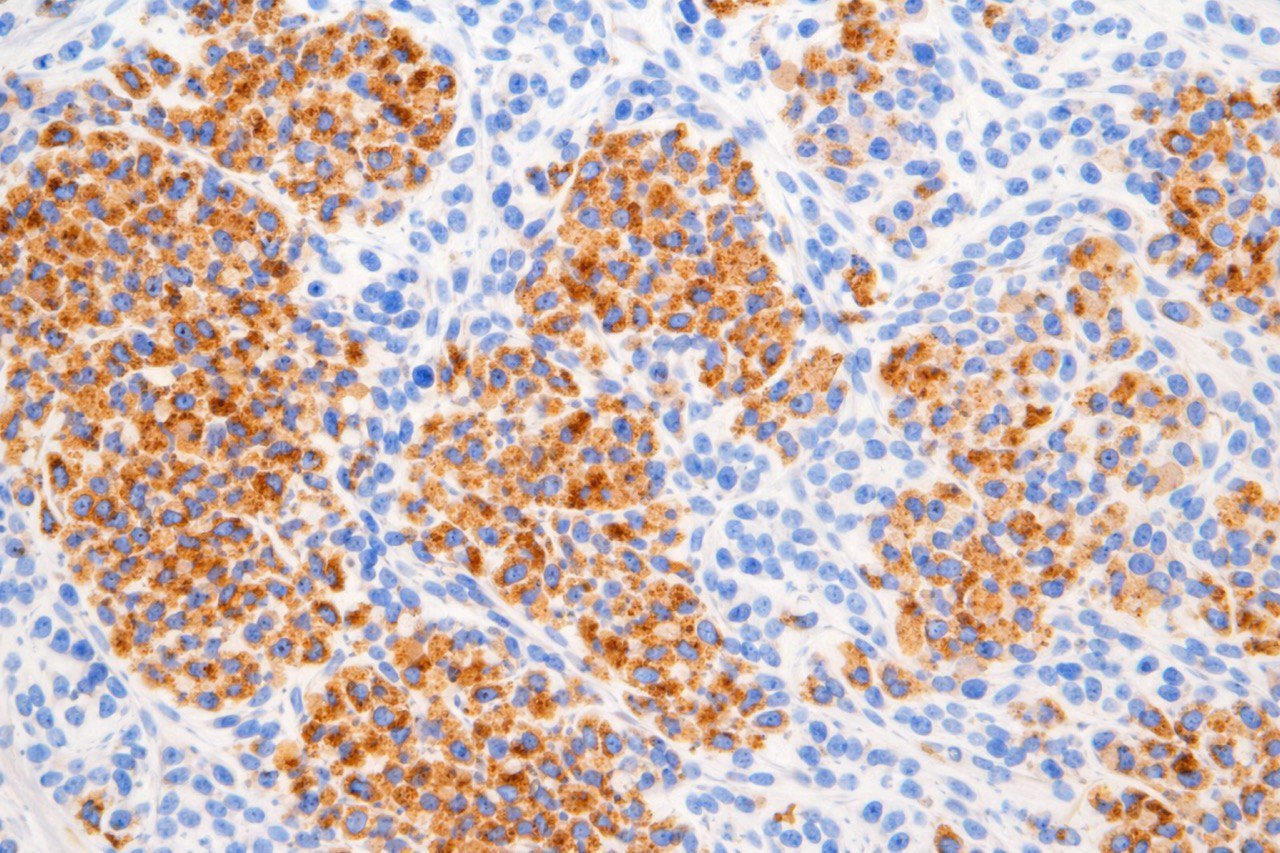

Send a message.
Email Center:
info@visionofresearch.ae
Call Center:
+971 425 44824
Academic & Research Platforms
University & Discovery-Oriented Services
Preclinical Drug Evaluation Platforms
Regulatory & Decision-Ready Services
1.End-to-End Research Project Design
2.Scientific Positioning & Topic Strategy
3.Hypothesis & Research Question Engineering
4.Study Methodology & Experimental Workflow
5.Statistical Design & Power Analysis
6.Biomarker, Gene & Target Strategy
7.Assay Selection & Validation Planning
8.Translational & Regulatory Alignment
9.Risk Management, Quality & Reproducibility
10.Data Analysis, Reporting & Scientific Support
1.Neurology & Neuroscience
2.Metabolic & Endocrine Models
3.Cardiovascular & Stroke Models
4.Reproductive & Fertility Models
5.Immunology & Inflammation
6.Liver & Kidney Disease Models
7.Gastrointestinal & Microbiome
8.Regenerative & Wound Healing
9.Toxicology & Safety Models
10.Ocular & Retinal Disease Models
11.Respiratory Disease Models
12.Musculoskeletal & Arthritis Models
13.Urology & Renal Function Models
14.Ocular & Retinal Disease Models
1.Learning, Memory & Cognition
2.Anxiety & Stress Behavior Assessment
3.Depression & Motivation Behavior
4.Pain & Nociception Assessment
5.Motor Function & Coordination
6.Sensorimotor Integration & Reflexes
7.Seizure & Epilepsy-Related Behavior
8.Sleep & Circadian Rhythm
9.Social Behavior & Communication
10.Reward, Addiction & Motivation
11.Fatigue & Exercise Capacity
12.Gastrointestinal & Feeding Behavior
13.Metabolic & Energy Balance
14.Urinary & Bladder Function
15.Cardiovascular Function & Stroke
16.Regenerative Functional Readouts
17.General Activity, Locomotion
Clinical Monitoring
- General Appearance & Condition
- Behavior & Stress Indicators
- Grooming & Coat Condition
- Respiratory Patterns & Function
- Toxicity & Distress Signs
- Body Weight & Growth Monitoring
- Food Intake & Nutritional Status
- Hydration & Fluid Balance
Hematological & Biochemical
- Complete Blood Count (CBC)
- Clinical Biochemistry Panels
- Electrolyte
1.Gene Expression (PCR-based)
2.Nucleic Acid Extraction & Synthesis
3.Design of Nucleotide Primer Sequences
4.PCR & Advanced Molecular Analysis
5.DNA & RNA Quantification
6.Agarose Gel Electrophoresis Performance
7.Epigenetic and DNA Methylation Assays
8.Transcriptomic and RNA-Seq Analysis
9.CRISPR-Based Genetic Validation Assays
10.Protein Expression (WB)
11.Biomarker Quantification (ELISA)
1.Cell Line Preparation & Treatment
2.Cell Viability, Proliferation & Cytotoxicity
3.Cell Migration, Invasion & Angiogenesis
4.Flow Cytometry & Cell Fate Analysis
5.Oxidative Stress & Drug Response
6.Cell Labeling, Tracking & Differentiation
7.Imaging & Microscopy
8.Organ-on-a-Chip & Advanced In-Vitro Models
9.Advanced Cellular & Molecular Platforms
10.Protein, Antibody & Omics-Related Services
1.IHC, IF & TUNEL assay
2.Fluorescent Staining Techniques
3.Specialized Staining Techniques
- Structural and Morphological Tissue
- Fibrosis and Extracellular Matrix
- Neurodegeneration & Neural Integrity
- Metabolic Changes & Lipid Accumulation
- Mineralization and Calcification
- Vascular Structure and Elastic Fibers
- Inflammation & Immune Response
- Vital Function & Cellular Differentiation
- Microbiological Staining Techniques
- Microscopic Imaging Platforms
1.Quantitative Analysis & Reporting
2.Tissue Evaluation & Analysis
3.Qualitative & Semi-Quantitative Analysis
4.Scientific & Regulatory Support
1.Isolation, Culture & Identification
2.Biochemical & Phenotypic Characterization
3.Antimicrobial & Antibiotic Evaluation
4.Mechanism of Action & Antimicrobial Resistance
5.Applied & Industrial Microbiology Services
1.Plant Extraction
2.Plant Extract Drying
3.Essential Oil Synthesis
4.Nanoparticle Synthesis
5.Exosome Isolation
- Neurology & Neuroscience
- Metabolic & Endocrine Models
- Cardiovascular & Stroke Models
- Reproductive & Fertility Models
- Immunology & Inflammation
- Liver & Kidney Disease Models
- Gastrointestinal & Microbiome
- Regenerative & Wound Healing
- Toxicology & Safety Models
- Ocular & Retinal Disease Models
- Respiratory Disease Models
- Musculoskeletal & Arthritis Models
- Urology & Renal Function Models
- Ocular & Retinal Disease Models
- Learning, Memory & Cognition
- Anxiety & Stress Behavior Assessment
- Depression & Motivation Behavior
- Pain & Nociception Assessment
- Motor Function & Coordination
- Sensorimotor Integration & Reflexes
- Seizure & Epilepsy-Related Behavior
- Sleep & Circadian Rhythm
- Social Behavior & Communication
- Reward, Addiction & Motivation
- Fatigue & Exercise Capacity
- Gastrointestinal & Feeding Behavior
- Metabolic & Energy Balance
- Urinary & Bladder Function
- Cardiovascular Function & Stroke
- Regenerative Functional Readouts
- General Activity, Locomotion
Daily Clinical Monitoring
- General Appearance & Condition
- Behavior & Stress Indicators
- Grooming & Coat Condition
- Respiratory Patterns & Function
- Toxicity & Distress Signs
- Body Weight & Growth Monitoring
- Food Intake & Nutritional Status
- Hydration & Fluid Balance
Hematological & Biochemical
- Complete Blood Count (CBC)
- Clinical Biochemistry Panels
- Electrolyte & Mineral Balance
- Tissue Sample Preparation & Processing
- Imaging Systems & Analysis Platforms
- IHC, IF & TUNEL assay
- Fluorescent Staining Techniques
- Specialized Staining Techniques
- Structural and Morphological Tissue
- Fibrosis and Extracellular Matrix
- Neurodegeneration & Neural Integrity
- Metabolic Changes & Lipid Accumulation
- Mineralization and Calcification
- Vascular Structure and Elastic Fibers
- Inflammation & Immune Response
- Vital Function & Cellular Differentiation
- Microbiological Staining Techniques
- Microscopic Imaging Platforms
- Qualitative & Semi-Quantitative Analysis
- Scientific & Regulatory Support
- Quantitative Analysis & Reporting
- Discovery & Target Identification
- In Vivo Functional Characterization
- Exposure–Response Confirmation
- Mechanistic Validation & Pathway Mapping
- Strategic Biomarker Prioritization
- Cell Viability & Cytotoxicity Screening
- Mechanistic & Molecular Pathway Assays
- Target Engagement & Binding Studies
- Functional Potency & Cellular Response
- In Vitro ADME & Metabolic Stability
- Advanced 3D & Complex Cellular Models
- Immunogenicity & Immunotoxicity Assessment
- Biophysical & Chemical Stability Profiling
- Preclinical-to-Clinical Biomarker Strategy
- Translational Correlation (In Vivo ↔ Clinical)
- Clinical Assay Development & Optimization
- Biomarker Strategy for Clinical Development
- Regulatory-Ready Biomarker Documentation
- PK/PD & Clinical Pharmacology
- Core PK/TK Assessment Framework
- PK Sampling Timepoint Design & Optimization
- Bioanalytical Platforms & Methods
(Modality-Specific Detection Platforms)
- Primary PK Objectives
- PK–PD Modeling & Simulation
(The Quantitative Engine for Rational Dosing)
- Biodistribution & Tissue Mapping Studies
- Specialized In Vitro ADME Analysis
- In Vivo Pharmacokinetic Studies
- Macromolecule (Biologics) Bioanalysis
- Small-Molecule Drug Bioanalysis
- Custom Drug Quantification Method Development
- Target Engagement & Pathway Modulation Assays
- Physicochemical Stability & Degradation Profiling
- Functional Potency & Biological Activity Assessment
- Receptor Binding Kinetics & Affinity Measurement
- Inflammatory Pathway Assessment
- Oxidative Stress & Antioxidant Profiling
- Metabolic Function & Hormonal Analysis
- Fibrosis & Extracellular Matrix Evaluation
- Apoptosis & Cellular Proliferation Monitoring
- Vascular Function & Angiogenesis Studies
- Immune Response & Activation Profiling
- FDA, U.S. Food & Drug Administration
- EMA, European Medicines Agency
- GCC Regulatory Authorities (GCC-DR, Saudi/GCC Union)
- SFDA, Saudi Food & Drug Authority
- MOHAP, Ministry of Health & Prevention (UAE)